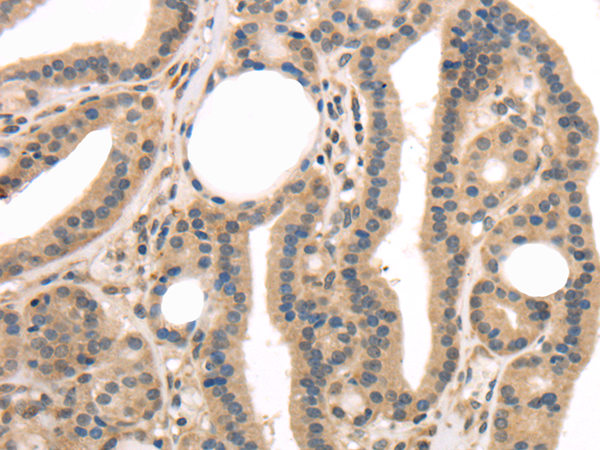

-
分类: 科研抗体货号: P08895别名: TPS2; tryptaseB; tryptaseC应用: WB,IHC反应种属: Human
-
分类: 科研抗体货号: P08878别名: Tp24; Il1rl1l; IL1RL1LG应用: WB,IHC反应种属: Human, Mouse, Rat
-
分类: 科研抗体货号: P08894别名: TP1; TLP1; p240; TROVE1; VAULT2应用: IHC反应种属: Human
-
分类: 科研抗体货号: P08877别名: TLS; ALS6; ETM4; FUS1; POMP75; HNRNPP2应用: IHC反应种属: Human, Mouse
-
分类: 科研抗体货号: P08912别名: OIP1; OIP-1; ZRP-1; TRIP-6; TRIP6i2应用: IHC反应种属: Human, Mouse
-
分类: 科研抗体货号: P08876别名: HsHPK; MRD57; PKU-ALPHA应用: WB,IHC反应种属: Human, Mouse
-
分类: 科研抗体货号: P08893别名: TR-1; H7365; C9orf2; CT120.1应用: IHC反应种属: Human, Mouse, Rat
-
分类: 科研抗体货号: P08911别名: My049; C20orf37; dJ794I6.3; HLC14-06-P应用: WB,IHC反应种属: Human, Mouse, Rat
-
分类: 科研抗体货号: P08892别名: NDED; GG2-1; SCCS2; SCC-S2; MDC-3.13应用: IHC反应种属: Human, Mouse
-
分类: 科研抗体货号: P08910别名: TRIP; RNF206应用: IHC反应种属: Human

鄂公网安备42018502007531号
鄂公网安备42018502007531号

